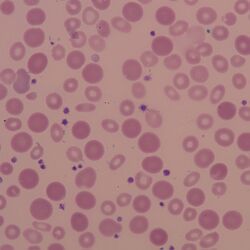

Anisochromia
From haematologyetc.co.uk
Derivation: From the Greek Aniso (unequal) and Greek Chromia (referring to colour or shade)
Description
This is a simple term that describes variation of colour between the red cells on blood smears; the term does not imply the nature of that variation or a pathological cause – just that different red cell have a different shade!
Appearance: Variability in colour can have many causes, these two images show normochromic, hypochromic and polychromatic cells together in the same image.
Pitfalls
The main pitfall is that the term is selected to describe the appearances of a film but falls short of describing what is happening: cells that may contribute to variation in color may include: dense hyperchromic erythrocytes, hypochromic erythrocytes, reticulocytes or stippled cells – these should be identified individually.
Recommendation
The term is better avoided when used alone: it is generally more useful to indicate the precise types of cells present. The example images show films that could be described as “anisochromic”, but note that in each case there are more specific terms that describe the cell types that contribute to the appearance.
Gallery
Clinical Image 1: Variation in colour and size in this image is caused by a combination of severe hypochromia, polychromasia, and partial transfusion. Clinical condition: Partly treated severe thalassaemia (hydrops)
Clinical Image 2: The variable colour in this case reflects a dimorphic blood film with hypochromic and transfused cells - more accurately described as dimorphic. Clinical condition: transfused severe iron deficiency.